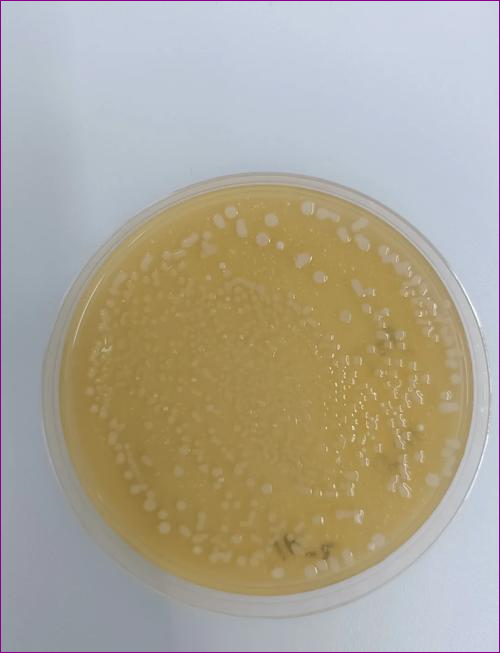

Bnr17 유산균 내돈내산 다이어트 효과 찐후기
2025.10.16

Bnr17 유산균 내돈내산 다이어트 효과 찐후기 안녕하세요~ 요즘 Bnr17에 대한 관심이 정말 많아지고 있던...
출처
https://blog.naver.com/kkm791004/224018626665
이슈모어 핫이슈
-
 참교육 홍종찬 감독 신작 퍼스트 닥터 합류한 하윤경, 장겨울 넘어 다시 의사가운 입는다
하윤경 퍼스트 닥터 합류 소식이 전해지며 배우 하윤경의 새로운 연기 변신에 관심이 모이고 있다. ‘슬기로운 …
참교육 홍종찬 감독 신작 퍼스트 닥터 합류한 하윤경, 장겨울 넘어 다시 의사가운 입는다
하윤경 퍼스트 닥터 합류 소식이 전해지며 배우 하윤경의 새로운 연기 변신에 관심이 모이고 있다. ‘슬기로운 …
-
 옥택연 일등머슴 용길이 결혼 후 첫 사극 복귀작으로 선택한 이유
옥택연 일등머슴 용길이 출연 소식이 전해지며 가수 겸 배우 옥택연의 새로운 행보에 관심이 집중되고 있다. 오…
옥택연 일등머슴 용길이 결혼 후 첫 사극 복귀작으로 선택한 이유
옥택연 일등머슴 용길이 출연 소식이 전해지며 가수 겸 배우 옥택연의 새로운 행보에 관심이 집중되고 있다. 오…
-
 배현성 여고생왕후 주연 행보 이어간다, 웹툰 원작 판타지 로맨스로 또 한 번 변신
배현성 여고생왕후 출연 소식이 전해지며 배우 배현성의 차기 행보에 관심이 집중되고 있다. 다양한 작품을 통해…
배현성 여고생왕후 주연 행보 이어간다, 웹툰 원작 판타지 로맨스로 또 한 번 변신
배현성 여고생왕후 출연 소식이 전해지며 배우 배현성의 차기 행보에 관심이 집중되고 있다. 다양한 작품을 통해…
관련 포스팅
Copyright blog.dowoo.me All right reserved.